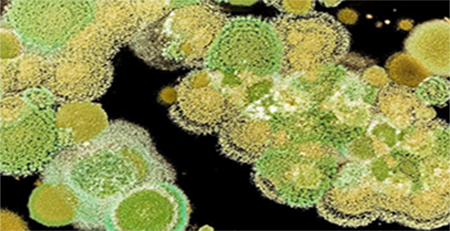
霉菌 霉菌

一定要知道的霉菌的危害!
發布時間:2021-01-05 點擊次數:3070
霉菌的存在都有哪些危害你知道嗎?防霉劑廠家告訴你當家里家具或者是墻體出現霉菌時,我們就要引起一定的重視,因為霉菌會給人帶來極大的危害,長期接觸和吸入霉菌都會嚴重影響人的身體健康,癥狀如:過 敏反應、支氣 管炎、扁桃體炎、鼻粘膜炎、流行性感冒、哮 喘病等等。
而對于免疫力較低的人群而言,他們是蕞容易受到霉菌侵害的,防霉劑廠家提示(這里包括孕婦、嬰幼兒、老年人),所以如果家里發現霉菌、腐爛真菌、變色真菌等菌落,都應及時處理掉,以免對人體健康造成影響。
防霉劑廠家提醒:造成發霉現象的霉菌,不僅會釋放出過 敏物質,引發過 敏,霉菌中還隱藏大量肝 炎病毒、流感病毒等,有些還會引起嚴重的肺部病 變,甚至死 亡。我國因氣候條件、建筑質量及家庭環境等眾多因素的影響,家庭霉菌的污染狀況要遠遠高于其他國家。
上一篇:
床墊發霉如何處理,霉菌對身體有危害嗎?
下一篇:室內外裝飾板發霉的防霉措施!
